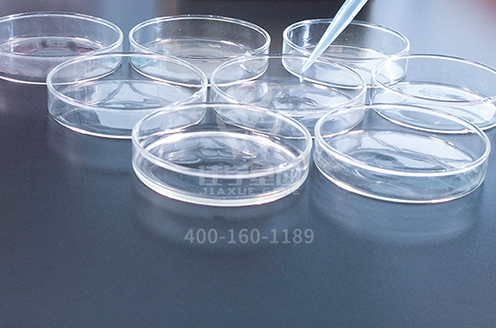
【佳学基因-基因检测】天气干燥，该给你的身体补水了

冬将至,你真的会喝水么?

每天八杯水,美丽一辈子!尽管大家都知道水这么重要,但很多人只是求量,却不知道这八杯水应该如何科学的补充。
《中国水与生命质量认知调查报告》显示,95.3%的人不会喝水,65.9%的人渴了才喝水,只有不到5%的人有定时定量喝水的好习惯。
找准喝水时机,才能够事半功倍。
小伙伴们,注意啦!注意啦!这里有好货哦!
感冒发烧
多喝水不仅促使排汗和排尿,而且有利于体温调节,促使体内病菌迅速排出。人在高烧时,会以出汗的形式散热,消耗大量水分。此时可少量多次地喝温开水或温葡萄糖水,小米粥、绿豆汤也是不错的选择。
便秘
便秘的主要原因有两条:一是体内有宿便,缺乏水分;二是肠道等器官没有排泄力。便便70%都是水分,若身体缺水,便便中的水分就会被大肠吸收,导致便便干燥,排泄不畅。建议便秘的小伙伴们每天喝2升水,分成8~10次喝,同时多吃芹菜等富含膳食纤维的蔬菜。
肥胖
如果你也有肥胖的困扰,或者想要保持苗条性感的好身材,可以选择在饭前半小时左右喝一小杯水,以增加饱腹感;饭后半小时,再喝一小杯水,加强身体的消化功能。
痛风
痛风多是因为人体内尿酸增多或排泄减少,尿酸盐沉积在关节、肾脏等部位造成的。喝水少会导致尿酸不能顺利排出体外,患病风险增高。专家建议,痛风病人可多喝富含锶、钙的矿泉水。

呕吐
呕吐是在人体摄入了不洁的食物后,自我保护的一种表现。为了避免严重呕吐或腹泻后引起的脱水症状,可以适当喝些淡盐水来补充体力,缓解虚弱状态。
排毒
人在早晨起床后会处于生理性缺水状态。每天清晨的领先件事就应该是空腹喝一杯水,只需要20秒,水分就能进入血液中,使血液迅速稀释,改善夜间脱水情况。要知道,人体经过了一宿的代谢,体内的垃圾需要外力 的帮助才能排除,谁就是最好的“清洗剂”。
睡前
老人临睡前适当喝点水,可以减少血液黏稠度,从而降低脑血栓的风险。人熟睡时,体内水分会通过排尿、出汗、呼吸不断丢失,造成血液黏稠度升高代谢物积存。临睡前适度喝水可缓解该现象,降低脑血栓等发病风险,尤其是老年人,不能因为怕起夜而拒绝睡前喝水。
洗澡后
洗完热水澡后, 身体受热血管扩张,血流量增加,心脏跳动会比平时快些,喝水应特别小心。最好小口慢速喝下一杯温水,否则容易增加心脏负担。

运动后
最好过几分钟,等心脏跳动稍微平稳后,再接着小口小口的喝些温开水。喝水时,尽量保持速度平缓,喝水的频率最好于心跳频率接近在间歇式的分多次喝。
如果高血压、高血脂、高血糖患者饮水不足,血液黏稠度会升高,血液循环变慢,容易引发心肌梗死、脑血栓等。建议“三高”患者多喝镁含量高的水。
开空调半小时后
空调房内空气干燥,容易造成人体水分流失,鼻腔等处黏膜过干,甚至引发支气管炎。
因此,在空调房逗留超过半小时,就要及时补充水分,白开水、矿泉水、柠檬水等。
尿变黄时
尿液呈浅黄色表明喝水量足够;若尿液比较黄,就要立刻饮水500毫升左右;若尿液呈土黄色,说明已经严重脱水,需要及时补水并去医院治疗。